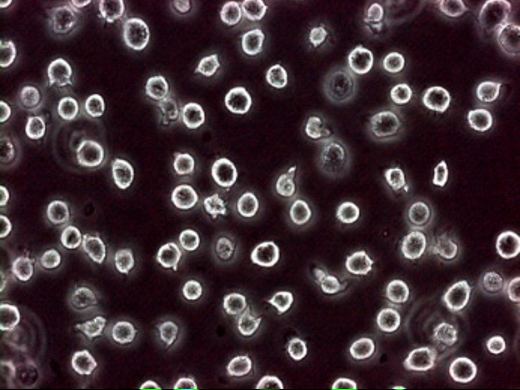

Hydrogen Peroxide (H2O2) Detection Probes
Hydrogen peroxide is a type of reactive oxygen species. When hydrogen peroxide reacts with iron or other transition metals in vivo, hydroxyl radicals are generated, causing damage to DNA, proteins, lipids, and other biomolecules.
Fluorescence probe-based methods are widely used to detect hydrogen peroxide because they enable real-time monitoring of trace amounts of hydrogen peroxide present in cells. Common fluorescent probes for hydrogen peroxide include DCFH and DCFH-DA. However, these probes exhibit limited specificity for H2O2.
Fujifilm Wako offers BES-H₂O₂-Ac and BES-H2O2 which are fluorescent probes for the detection of hydrogen peroxide in living cells. Compared with the conventional fluorescent probe DCFH, they exhibit greater specificity for hydrogen peroxide.
What is Hydrogen Peroxide (H2O2)?
Hydrogen peroxide (H2O2) is a type of reactive oxygen species formed by the two-electron reduction of molecular oxygen. In biological systems, H2O2 is primarily generated through the dismutation of superoxide (O2⁻・) catalyzed by superoxide dismutase (SOD). When hydrogen peroxide reacts with iron or other transition metals in vivo, hydroxyl radicals (・OH) are generated, causing damage to DNA, proteins, lipids, and other biomolecules. Therefore, cells must eliminate H2O2, a role primarily fulfilled by catalase, which catalyzes the dismutation of hydrogen peroxide into water and oxygen.
Hydrogen peroxide is more stable than other reactive oxygen species such as superoxide, and a variety of measurement methods have been established that utilize enzymes such as catalase, peroxidase, and alcohol dehydrogenase1). Among these approaches, fluorescence probe–based methods are widely used in the life sciences because they enable real-time monitoring of trace amounts of hydrogen peroxide present in cells. Common fluorescent probes for hydrogen peroxide include dichlorodihydrofluorescein (DCFH) and its diacetylated derivative, DCFH-DA. DCFH is oxidized by H2O2 in the presence of peroxidase or heme-containing proteins to produce the fluorescent compound dichlorofluorescein (DCF)1). However, these probes exhibit limited specificity for H2O2, and have been reported to be activated by hydroperoxides in the presence of peroxidase, nitric oxide, or peroxynitrite2). Consequently, a strong need exists for the development of fluorescent probes with improved specificity for hydrogen peroxide.
BES-H2O2-Ac/BES-H2O2
BES-H2O2-Ac and BES-H2O2 are fluorescent probes for the detection of hydrogen peroxide (H2O2) in living cells2). Compared with the conventional fluorescent probe dichlorodihydrofluorescein (DCFH), they exhibit greater specificity for hydrogen peroxide, resulting in reduced background fluorescence. These probes are suitable for live-cell imaging by fluorescence microscopy as well as for analysis by flow cytometry.
Features
- Detection of hydrogen peroxide in living cells
- Higher specificity for hydrogen peroxide than conventional fluorescent probes (DCFH)
- Water-soluble, allowing direct use in aqueous media
- Ex/Em=485±20 nm/515±20 nm
Principle

Data
Detection of Hydrogen Peroxide in Jurkat T cells with BES-H2O2-Ac
Jurkat T cells were incubated in medium containing 50 µM BES-H2O2-Ac at 37°C for 1 hour to allow cellular uptake of the reagent. Subsequently, hydrogen peroxide production was induced by the addition of 5 mM butyrate, followed by an additional 1-hour incubation.
| Without H2O2 production | With H2O2 production | |
| Fluorescence image | ![]() |
![]() |
| Phase-contrast image | ![]() |
![]() |
References
- 「活性酸素実験プロトコール」ed. by Suma, H., Shujunsha, Tokyo, p.18(1994). (Japanese)
- Maeda, H. et al.: Angew. Chem. Int. Ed., 43, 239(2004).
Fluorescent probes for hydrogen peroxide based on a non-oxidative mechanism
Product List
- Open All
- Close All
BES-H2O2-Ac (Cell-permeant)
BES-H2O2 (Cell-impermeant)
2',7'-Dichlorofluorescein (DCF)
For research use or further manufacturing use only. Not for use in diagnostic procedures.
Product content may differ from the actual image due to minor specification changes etc.
If the revision of product standards and packaging standards has been made, there is a case where the actual product specifications and images are different.